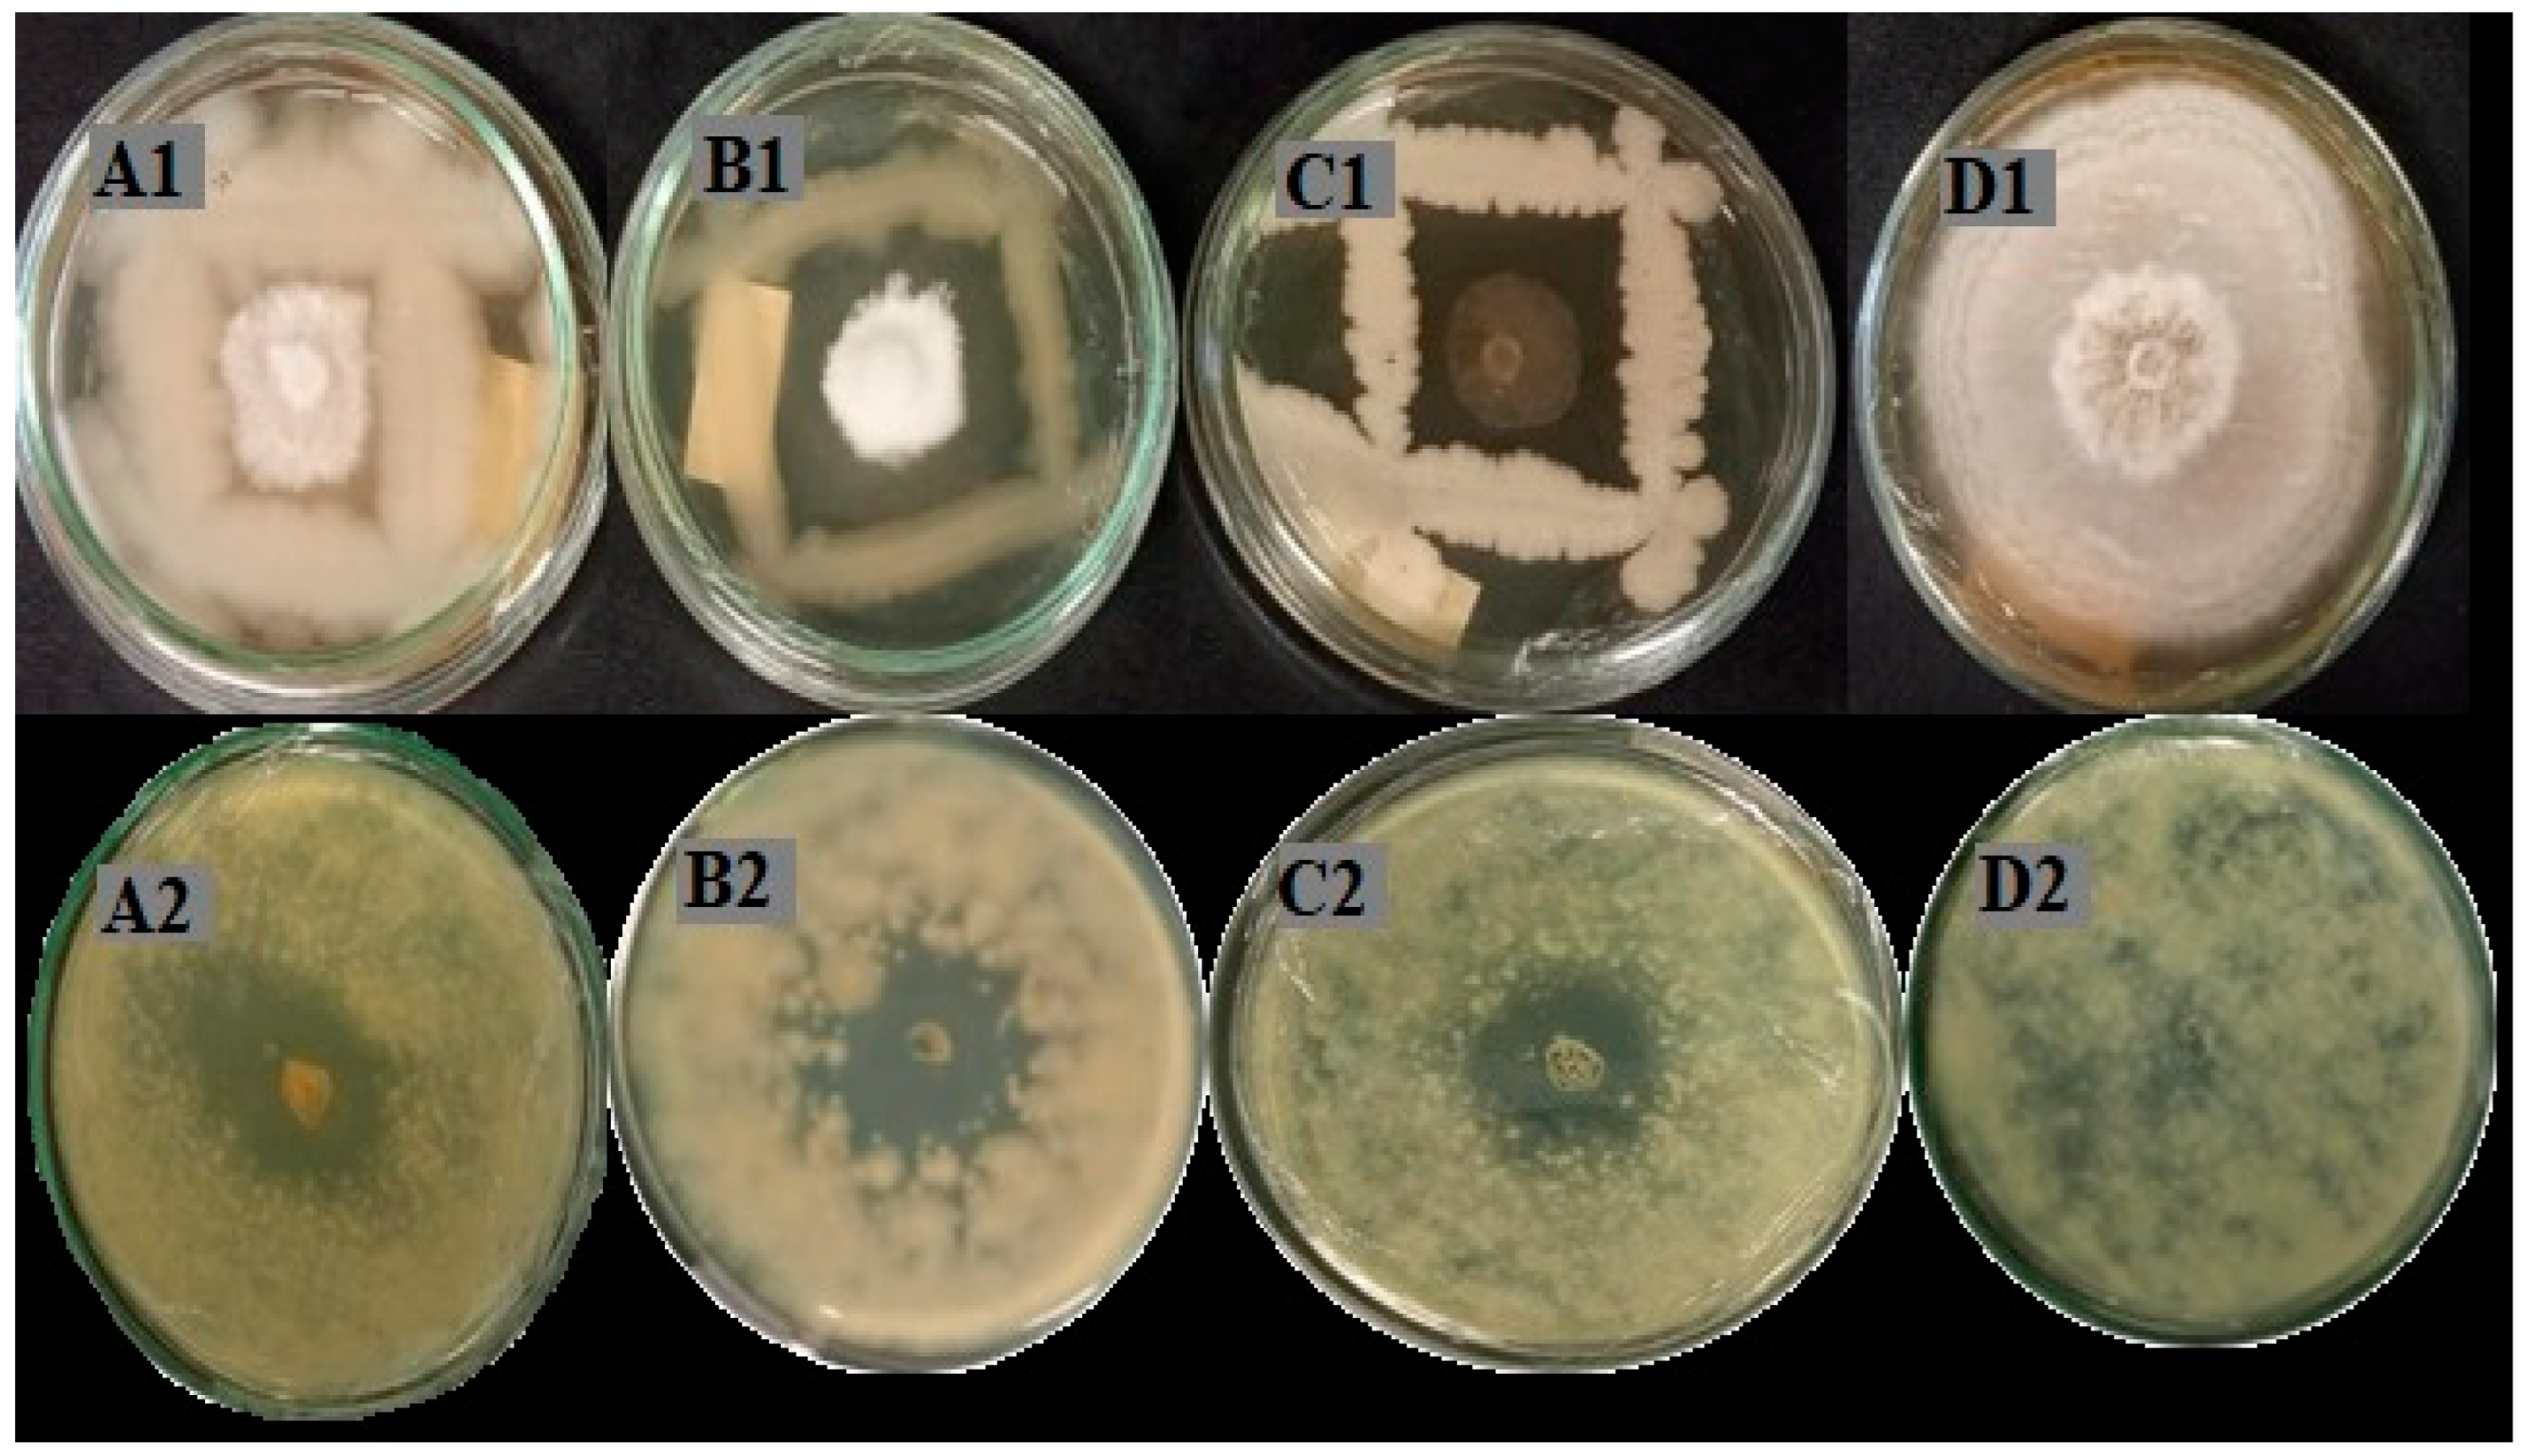
Agronomy 15 00569 g001

Bacillus Strains Isolated from Agroforestry Systems in the Amazon Promote Açaí Palm Seedling Growth When Inoculated as a Consortium
Abstract
1. Introduction
2. Materials and Methods
2.1. Field Experiment and Sampling Conditions
2.2. Isolation of Bacterial Strains
2.3. Molecular Identification of Bacterial Strains
2.4. Screening of Rhizobacteria for Plant Growth Promoter Traits
2.5. Extraction of Bacterial Bioactive Components
2.6. Antagonistic Potential of Crude Extracts
2.7. In Vivo Plant Growth Promotion Test Using Açaí Seeds
3. Results
3.1. Isolation and Identification of Bacterial Strains
3.2. Production of Siderophores and Indole Acetic Acid (IAA), Organic Phosphate Mineralization, and Inorganic Phosphate Solubilization and Antimicrobial Substances (AMS)
3.3. Antifungal Potential of Crude Extracts
3.4. In Vitro Germination of Açaí Seeds
4. Discussion
5. Conclusions
Supplementary Materials
Author Contributions
Funding
Data Availability Statement
Acknowledgments
Conflicts of Interest
References
- Monroe, P.H.M.; Gama-Rodrigues, E.F.; Gama-Rodrigues, A.C.; Marques, J.R.B. Soil carbon stocks and origin under different cacao agroforestry systems in Southern Bahia, Brazil. Agric. Ecosyst. Environ. 2016, 221, 99–108. [Google Scholar] [CrossRef]
- Marsden, C.; Martin-Chave, A.; Cortet, J.; Hedde, M.; Capowiez, Y. How agroforestry systems influence soil fauna and their functions-a review. Plant Soil 2020, 453, 29–44. [Google Scholar] [CrossRef]
- Tregidgo, D.; Campbell, A.J.; Rivero, S.; Freitas, M.A.B.; Almeida, O. Vulnerability of the Açaí palm to climate change. Hum. Ecol. 2020, 48, 505–514. [Google Scholar] [CrossRef]
- Carvalho, R.D.C.; Alves, L.D.F.N.; Carneiro, R.D.V. Forest restoration in the floodplains of the Amazon estuary subjected to intensive açaí management. Environ. Soc. 2021, 24, 02693. [Google Scholar] [CrossRef]
- Damasco, G.; Anhalt, M.; Perdiz, R.O.; Wittmann, F.; De Assis, R.L.; Schongart, J.; Fine, P.V. Certification of açaí agroforestry increases the conservation potential of the Amazonian tree flora. Agrofor. Syst. 2022, 96, 407–416. [Google Scholar] [CrossRef]
- Vasconcellos, R.C.; Beltrão, N.S.; Martins, S.S.; Paula, M.T. Identification of ecosystem services in agricultural production: A study in agroforestry systems. Res. Soc. Dev. 2020, 9, e9259109268. [Google Scholar] [CrossRef]
- Sousa, R.D.S.D.R.D.; Lima, G.V.S.; Garcias, J.T.; Gomes, G.D.O.; Mateus, J.R.; Madeira, L.D.P.D.S.; Lucy, S.; Rogez, H.L.G.; Marques, J.M. The Microbial Community Structure in the Rhizosphere of Theobroma cacao L. and Euterpe oleracea Mart. Is Influenced by Agriculture System in the Brazilian Amazon. Microorganisms 2024, 12, 398. [Google Scholar] [CrossRef]
- Gouda, S.; Kerry, R.G.; Das, G.; Paramithiotis, S.; Shin, H.S.; Patra, J.K. Revitalization of plant growth promoting rhizobacteria for sustainable development in agriculture. Microbiol. Res. 2018, 206, 131–140. [Google Scholar] [CrossRef]
- Nagrale, D.T.; Chaurasia, A.K.S.; Gawande, S.P.; Hiremani, N.S.; Sankar, R. PGPR: The treasure of multifarious beneficial microorganisms for nutrient mobilization, pest biocontrol and plant growth promotion in field crops. World J. Microbiol. Biotechnol. 2023, 39, 10. [Google Scholar] [CrossRef] [PubMed]
- Bhattacharyya, C.; Bakshi, U.; Mallick, I.; Mukherji, S.; Bera, B.; Ghosh, A. Genome-guided insights into the plant growth promotion capabilities of the physiologically versatile Bacillus aryabhattai strain AB211. Front. Microbiol. 2017, 8, 411. [Google Scholar] [CrossRef]
- Lebrazi, S.; Niehaus, K.; Bednarz, H.; Fadil, M.; Chraibi, M.; Fikri-Benbrahim, K. Screening and optimization of indole-3-acetic acid production and phosphate solubilization by rhizobacterial strains isolated from Acacia cyanophylla root nodules and their effects on its plant growth. J. Genet. Eng. Biotechnol. 2020, 18, 71. [Google Scholar] [CrossRef]
- Backer, R.; Rokem, J.S.; Iiangumaran, G.; Lamont, J.; Praslickova, D.; Ricci, E.; Smith, D.L. Plant growth-promoting rhizobacteria: Context, mechanisms of action, and roadmap to commercialization of biostimulants for sustainable agriculture. Front. Plant Sci. 2018, 9, 14–73. [Google Scholar] [CrossRef]
- Santoyo, G.; Urtis-Flores, C.A.; Loeza-Lara, P.D.; Orozco-Mosqueda, M.D.C.; Glick, B.R. Rhizosphere colonization determinants by plant growth-promoting rhizobacteria (PGPR). Biology 2021, 10, 475. [Google Scholar] [CrossRef] [PubMed]
- Vocciante, M.; Grifoni, M.; Fusini, D.; Petruzzelli, G.; Franchi, E. The role of plant growth-promoting rhizobacteria (PGPR) in mitigating plant’s environmental stresses. Appl. Sci. 2022, 12, 1231. [Google Scholar] [CrossRef]
- Bai, Y.C.; Li, B.X.; Xu, C.Y.; Raza, M.; Wang, Q.; Wang, Q.Z.; Xu, Y.J. Intercropping walnut and tea: Effects on soil nutrients, enzyme activity, and microbial communities. Front. Microbiol. 2022, 13, 852342. [Google Scholar] [CrossRef]
- Da Silva Maia, R.; Vasconcelos, S.S.; Viana-Junior, A.B.; Castellani, D.C.; Kato, O.R. Oil palm (Elaeis guineensis) shows higher mycorrhizal colonization when planted in agroforestry than in monoculture. Agrofor. Syst. 2021, 95, 731–740. [Google Scholar] [CrossRef]
- Jain, A.; Sarsaya, S.; We, Q.; Lu, Y.; Shi, J. A review of plant leaf fungal diseases and its environment speciation. Bioengineered 2019, 10, 409–424. [Google Scholar] [CrossRef]
- Peters, L.P.; Prado, L.S.; Silva, F.I.; Souza, F.S.; Carvalho, C.M. Selection of endophytes as antagonists of Colletotrichum gloeosporioides in açaí palm. Biol. Control. 2020, 150, 104350. [Google Scholar] [CrossRef]
- De Castro, G.L.S.; Da Silva Júnior, D.D.; Viana, R.G.; Rêgo, M.C.F.; Da Silva, G.B. Photosynthetic apparatus protection and drought effect mitigation in açaí palm seedlings by rhizobacteria. Acta Physiol. Plant. 2019, 41, 163. [Google Scholar] [CrossRef]
- Martins, M.O.; Souza, T.; De Melo, I.R.; Da Silva, L.J.R. Physiological Traits and Biomass Production of two Euterpe Species under drought stress. Russ. J. Plant Physiol. 2023, 70, 80. [Google Scholar] [CrossRef]
- De Castro, G.L.S.; Rêgo, M.C.F.; Silvestre, W.V.D.; Batista, T.F.V.; Da Silva, G.B. Açaí palm seedling growth promotion by rhizobacteria inoculation. Braz. J. Microbiol. 2020, 51, 205–216. [Google Scholar] [CrossRef]
- Campos, T.S.; Patrício, M.P.; Vieira, G.R.; Souza, A.M.B.D.; Santos, C.H.B.; Rigobelo, E.C.; Pivetta, K.F.L. Rhizobacteria in growth and quality of açaí seedlings. Ornam. Hortic. 2023, 29, 208–215. [Google Scholar] [CrossRef]
- Claessen, M.E.C. Manual de métodos de análise de solo/Centro Nacional de Pesquisa de Solos.–2 ed. rev. Atual. In Documentos; EMBRAPA-CNPS: Rio de Janeiro, Brazil, 1997; Volume 1, 212p. [Google Scholar]
- Seldin, L.; Dubnau, D. Deoxyribonucleic acid homology among Bacillus polymyxa, Bacillus macerans, Bacillus azotofixans, and other nitrogen-fixing Bacillus strains. Int. J. Syst. Evol. Microbiol. 1985, 35, 151–154. [Google Scholar] [CrossRef]
- Rademaker, J.L.W.; Louws, F.J.; Rossbach, U.; Vinuesa, P.; De Bruijin, F.J. Computer-assisted pattern analysis of molecular fingerprints and database construction. Mol. Microb. Ecol. Man. 1999, 3, 1–33. [Google Scholar]
- Lane, D.J. 16S/23S rRNA sequencing. In Nucleic Acid Techniques in Bacterial Systematics; Stackebrandt, E., Goodfellow, M., Eds.; John Wiley & Sons: Hoboken, NJ, USA, 1991; pp. 115–147. [Google Scholar]
- Turner, S.; Pryer, K.M.; Miao, V.P.; Palmer, J.D. Investigating deep phylogenetic relationships among cyanobacteria and plastids by small subunit rRNA sequence analysis 1. J. Eukaryot. Microbiol. 1999, 4, 327–338. [Google Scholar] [CrossRef]
- Shwin, B.; Neilands, J.B. Universal chemical assay for the detection and determination of siderophores. Anal. Biochem. 1987, 160, 47–56. [Google Scholar]
- Rosado, A.S.; de Azevedo; da Cruz, D.W.; van Elsas. Phenotypic and genetic diversity of Paenibacillus azotofixans strains isolated from the rhizoplane or rhizosphere soil of different grasses. J. Appl. Microbiol. 1998, 84, 216–226. [Google Scholar] [CrossRef]
- Nautiyal, C.S. An efficient microbiological growth medium for screening phosphate solubilizing microorganisms. FEMS Microbiol. Lett. 1999, 170, 265–270. [Google Scholar] [CrossRef]
- Tang, Y.W.; Bonner, J. The enzymatic inactivation of indoleacetic acid. I. Some characteristics of the enzyme contained in pea seedlings. Arch. Biochem. Biophys. 1948, 13, 11–25. [Google Scholar]
- Mew, T.W.; Rosales, A.M. Bacterization of rice plants for control of sheath blight caused by Rhizoctonia solani. Phytopathology 1986, 76, 1260–1264. [Google Scholar] [CrossRef]
- Goswami, M.; Deka, S. Isolation of a novel rhizobacteria having multiple plant growth promoting traits and antifungal activity against certain phytopathogens. Microbiol. Res. 2020, 240, 126516. [Google Scholar] [CrossRef] [PubMed]
- Balouiri, M.; Sadiki, I.M.; Ibnsouda, S.K. Methods for in vitro evaluating antimicrobial activity: A review. J. Pharm. Anal. 2015, 6, 71–79. [Google Scholar] [CrossRef]
- Muhialdin, B.J.; Algoory, H.L.; Kadum, H.; Mohammed, N.K.; Saari, N.; Hassan, Z.; Hussin, A.S.M. Antifungal activity determination for the peptides generated by Lactobacillus plantarum TE10 against Aspergillus flavus in maize seeds. Food Control. 2020, 109, 106898. [Google Scholar] [CrossRef]
- Ferreira, C.D.; Silva-Cardoso, I.L.D.A.; Ferreira, J.C.B.; Costa, F.H.D.S.; Scherwinski-Pereira, J.F. Morphostructural and histochemical dynamics of Euterpe precatoria (Arecaceae) germination. J. Plant Res. 2020, 133, 693–713. [Google Scholar] [CrossRef]
- Yuan, X.; Wen, B. Seed germination response to high temperature and water stress in three invasive Asteraceae weeds from Xishuangbanna, SW China. PLoS ONE 2018, 13, 0191710. [Google Scholar] [CrossRef] [PubMed]
- De Almeida, J.R.; Bonatelli, M.L.; Batista, B.D.; Teixeira-Silva, N.S.; Mondin, M.; Dos Santos, R.C.; Quecine, M.C. Bacillus thuringiensis RZ2MS9, a tropical plant growth-promoting rhizobacterium, colonizes maize endophytically and alters the plant’s production of volatile organic compounds during co-inoculation with Azospirillum brasilense Ab-V5. Environ. Microbiol. Rep. 2021, 13, 812–821. [Google Scholar] [CrossRef] [PubMed]
- Nihorimbere, G.; Korangi Alleluya, V.; Nimbeshaho, F.; Nihorimbere, V.; Legrève, A.; Ongena, M. Bacillus-based biocontrol beyond chemical control in central Africa: The challenge of turning myth into reality. Front. Plant Sci. 2024, 15, 1349357. [Google Scholar] [CrossRef]
- Torres, C.M.M.E.; Jacovine, L.A.G.; Nolasco de Olivera Neto, S.; Fraisse, C.W.; Soares, C.P.B.; de Castro Neto, F.; Lemes, P.G. Greenhouse gas emissions and carbon sequestration by agroforestry systems in southeastern Brazil. Sci. Rep. 2017, 7, 16738. [Google Scholar] [CrossRef]
- Celentano, D.; Rousseau, G.X.; Paixão, L.S.; Lourenço, F.; Cardozo, E.G.; Rodrigues, T.O.; de Oliveira Reis, F. Carbon sequestration and nutrient cycling in agroforestry systems on degraded soils of Eastern Amazon, Brazil. Agrofor. Syst. 2020, 94, 1781–1792. [Google Scholar] [CrossRef]
- Tremblay, S.; Lucotte, M.; Revéret, J.P.; Davidson, R.; Mertens, F.; Passos, C.J.S.; Romana, C.A. Agroforestry systems as a profitable alternative to slash and burn practices in small-scale agriculture of the Brazilian Amazon. Agrofor. Syst. 2014, 89, 193–204. [Google Scholar] [CrossRef]
- Sabino, W.; Costa, L.; Andrade, T.; Teixeira, J.; Araújo, G.; Acosta, A.L.; Giannini, T.C. Status and trends of pollination services in Amazon agroforestry systems. Agric. Ecosyst. Environ. 2022, 335, 108012. [Google Scholar] [CrossRef]
- Stevens, V.; Thijs, S.; McAmmond, B.; Langill, T.; Van Hamme, J.; Weyens, N.; Vangronsveld, J. Draft genome sequence of Rhodococcus erythropolis VSD3, a diesel fuel-degrading and plant growth-promoting bacterium isolated from Hedera helix leaves. Genome Announc. 2017, 5, 10–1128. [Google Scholar] [CrossRef]
- Chhetri, G.; Kim, I.; Kang, M.; So, Y.; Kim, J.; Seo, T. An isolated Arthrobacter sp. enhances rice (Oryza sativa L.) plant growth. Microorganisms 2022, 10, 1187. [Google Scholar] [CrossRef] [PubMed]
- De, O.; Nunes, P.S.; De Medeiros, F.H.; De Oliveira, T.S.; de Almeida Zago, J.R.; Bettiol, W. Bacillus subtilis and Bacillus licheniformis promote tomato growth. Braz. J. Microbiol. 2023, 54, 397–406. [Google Scholar] [CrossRef] [PubMed]
- Visioli, G.; D’Egidio, S.; Vamerali, T.; Mattarozzi, M.; Sanangelantoni, A.M. Culturable endophytic bacteria enhance Ni translocation in the hyperaccumulator Noccaea caerulescens. Chemosphere 2014, 117, 538–544. [Google Scholar] [CrossRef] [PubMed]
- Bhattacharyya, P.N.; Goswami, M.P.; Bhattacharyya, L.H. Perspective of beneficial microbes in agriculture under changing climatic scenario: A review. J. Phytol. 2016, 8, 26–41. [Google Scholar] [CrossRef]
- Fira, D.; Dimkić, I.; Berić, T.; Lozo, J.; Stanković, S. Biological control of plant pathogens by Bacillus species. J. Biotechnol. 2018, 285, 44–55. [Google Scholar] [CrossRef]
- Caulier, S.; Nannan, C.; Gillis, A.; Licciardi, F.; Bragard, C.; Mahillon, J. Overview of the antimicrobial compounds produced by members of the Bacillus subtilis group. Front. Microbiol. 2019, 10, 435128. [Google Scholar] [CrossRef]
- Radhakrishnan, R.; Hashem, A.; Abd_Allah, E.F. Bacillus: A biological tool for crop improvement through bio-molecular changes in adverse environments. Front. Physiol. 2017, 8, 293128. [Google Scholar] [CrossRef]
- Singh, R.P.; Ma, Y.; Shadan, A. Perspective of ACC-deaminase producing bacteria in stress agriculture. J. Biotechnol. 2022, 352, 36–46. [Google Scholar] [CrossRef]
- Benaissa, A. Rhizosphere: Role of bacteria to manage plant diseases and sustainable agriculture—A review. J. Basic Microbiol. 2023, 64, 2300361. [Google Scholar] [CrossRef] [PubMed]
- Benchimol, R.L.; da Silva, C.M.; Santos, A. Pestalotiopsis sp. spots on seedlings of Euterpe precatoria. In Embrapa Amazônia Oriental—Proceedings Article (ALICE), no. 19. 3rd Postgraduate Seminar of Embrapa Amazônia Oriental; Embrapa Amazônia Oriental: Belém, PA, USA, 2015; Available online: https://portaldxp-h.sede.embrapa.br/busca-de-publicacoes/-/publicacao/1022812/mancha-de-pestalotiopsis-sp-em-mudas-de-euterpe-precatoria (accessed on 14 June 2024).
- Shen, H.F.; Zhang, J.X.; Lin, B.R.; Pu, X.M.; Zheng, L.; Qin, X.D.; Xie, C.P. First report of Pestalotiopsis microspora causing leaf spot of oil palm (Elaeis guineensis) in China. Plant Dis. 2014, 98, 1429. [Google Scholar] [CrossRef]
- Bhuiyan, M.A.B.; Sultana, N.; Mahmud, N.U.; Kader, M.A.; Hassan, O.; Chang, T.; Akanda, A.M. Characterization of Pestalotiopsis sp. causing gray leaf spot in coconut (Cocos nucifera L.) in Bangladesh. J. Basic Microbiol. 2021, 61, 1085–1097. [Google Scholar] [CrossRef]
- Jiang, N.; Voglmayr, H.; Xue, H.; Piao, C.G.; Li, Y. Morphology and phylogeny of Pestalotiopsis (Sporocadaceae, Amphisphaeriales) from Fagaceae leaves in China. Microbiol. Spectr. 2022, 10, e03272-22. [Google Scholar] [CrossRef]
- Zheng, X.; Liu, X.; Li, X.; Quan, C.; Li, P.; Chang, X.; Gong, G. Pestalotiopsis Species Associated with Blueberry Leaf Spots and Stem Cankers in Sichuan Province of China. Plant Dis. 2023, 107, 149–156. [Google Scholar] [CrossRef] [PubMed]
- Chen, Y.; Zeng, L.; Shu, N.; Jiang, M.; Wang, H.; Huang, Y.; Tong, H. Pestalotiopsis-like species causing gray blight disease on Camellia sinensis in China. Plant Dis. 2018, 102, 98–106. [Google Scholar] [CrossRef]
- Ali, M.A.; Ren, H.; Ahmed, T.; Luo, J.; An, Q.; Qi, X.; Li, B. Antifungal effects of rhizospheric Bacillus species against bayberry twig blight pathogen Pestalotiopsis versicolor. Agronomy 2020, 13, 1811. [Google Scholar] [CrossRef]
- Gardener, B.M.M. Ecology of Bacillus and Paenibacillus spp. in agricultural systems. Phytopathology 2004, 94, 1252–1258. [Google Scholar] [CrossRef] [PubMed]
- Li, L.; Tan, J.; Chen, F.; Hao, D. Colonization of Bacillus cereus NJSZ-13, a species with nematicidal activity in Masson pine (Pinus massoniana Lamb.). J. For. Res. 2020, 31, 1025–1033. [Google Scholar] [CrossRef]
- White Jr, J.F.; Torres, M.S.; Sullivan, R.F.; Jabbour, R.E.; Chen, Q.; Tadych, M.; Belanger, F.C. Occurrence of Bacillus amyloliquefaciens as a systemic endophyte of vanilla orchids. Microsc. Res. Tech. 2014, 77, 874–885. [Google Scholar] [CrossRef]
- Ramamoorthy, V.; Viswanathan, R.; Raguchander, T.; Prakasam, V.; Samiyappan, R. Induction of systemic resistance by plant growth promoting rhizobacteria in crop plants against pests and diseases. Crop Prot. 2001, 20, 1–11. [Google Scholar] [CrossRef]
- Kumar, A.; Singh, V.K.; Tripathi, V.; Singh, P.P.; Singh, A.K. Plant growth-promoting rhizobacteria (PGPR): Perspective in agriculture under biotic and abiotic stress. In Crop Improvement through Microbial Biotechnology; Elsevier: Amsterdam, The Netherlands, 2018; pp. 333–342. [Google Scholar] [CrossRef]
- Van Loon, L.C. Plant responses to plant growth-promoting rhizobacteria. In New Perspectives and Approaches in Plant Growth-Promoting Rhizobacteria Research; Springer: Berlin/Heidelberg, Germany, 2007; pp. 243–254. [Google Scholar] [CrossRef]
- Attia, M.S.; El-Sayyad, G.S.; Abd Elkodous, M.; El-Batal, A.I. The effective antagonistic potential of plant growth-promoting rhizobacteria against Alternaria solani-causing early blight disease in tomato plant. Sci. Hortic. 2020, 266, 109289. [Google Scholar] [CrossRef]
- Jiao, X.; Takishita, Y.; Zhou, G.; Smith, D.L. Plant associated rhizobacteria for biocontrol and plant growth enhancement. Front. Plant Sci. 2021, 12, 634796. [Google Scholar] [CrossRef]
- Sayyd, Z.; Das, K. Articulating beneficial rhizobacteria-mediated plant defenses through induced systemic resistance: A review. Pedosphere 2023, 33, 556–566. [Google Scholar] [CrossRef]
- Romero, D.; Pérez-García, A.; Rivera, M.E.; Cazorla, F.M.; De Vicente, A. Isolation and evaluation of antagonistic bacteria towards the cucurbit powdery mildew fungus Podosphaera fusca. Appl. Microbiol. Biotechnol. 2004, 64, 263–269. [Google Scholar] [CrossRef]
- Won, S.J.; Moon, J.H.; Ajuna, H.B.; Choi, S.I.; Maung, C.E.H.; Lee, S.; Ahn, Y.S. Biological control of leaf blight disease caused by Pestalotiopsis maculans and growth promotion of Quercus acutissima Carruth container seedlings using Bacillus velezensis CE100. Int. J. Mol. Sci. 2021, 20, 11296. [Google Scholar] [CrossRef]
- Tang, Y.; Kang, H.; Qin, Z.; Zhang, K.; Zhong, Y.; Li, H.; Mo, L. Significance of manganese resistant Bacillus cereus strain WSE01 as a bioinoculant for promotion of plant growth and manganese accumulation in Myriophyllum verticillatum. Sci. Total Environ. 2020, 707, 135867. [Google Scholar] [CrossRef] [PubMed]
- Dobrzyński, J.; Jakubowska, Z.; Kulkova, I.; Kowalczyk, P.; Kramkowski, K. Biocontrol of fungal phytopathogens by Bacillus pumilus. Front. Microbiol. 2023, 14, 1194606. [Google Scholar] [CrossRef]
- Jha, C.K.; SARAF, M. Plant growth promoting rhizobacteria (PGPR): A review. J. Agric. Res. Dev. 2015, 5, 108–119. [Google Scholar] [CrossRef]
- Vejan, P.; Abdullah, R.; Khadiran, T.; Ismail, S.; Nasrulhaq Boyce, A. Role of plant growth promoting rhizobacteria in agricultural sustainability: A review. Molecules 2016, 21, 573. [Google Scholar] [CrossRef]
- Seenivasagan, R.; Babalola, O.O. Utilization of microbial consortia as biofertilizers and biopesticides for the production of feasible agricultural product. Biology 2021, 10, 1111. [Google Scholar] [CrossRef] [PubMed]
- Lee, J.H.; Anderson, A.J.; Kim, Y.C. Root-associated bacteria are biocontrol agents for multiple plant pests. Microorganisms 2022, 10, 1053. [Google Scholar] [CrossRef] [PubMed]

| BOX-PCR Group | Strain | Closest Database Match (Accession Number), Identity (%) | Siderophore • | PO4 org | PO4 inorg | IAA | AMS | ||||
|---|---|---|---|---|---|---|---|---|---|---|---|
| Curvularia | Fusarium | Pestalotiopsis | Pythium | Rhizoctonia | |||||||
| 1 | AP2-21 * | Rhodococcus hoagi (X82052.1), 100 | − | − | − | − | − | − | − | − | − |
| AP1-37 | − | − | − | − | − | − | − | − | − | ||
| 2 | AP1-33 * | Bacillus cereus (MT125789.1), 100 | − | − | − | + | + | + | + | + | + |
| 3 | AP3-39 | Rhodococcus hoagi (X82052.1), 99 | − | − | − | − | − | − | − | − | − |
| AP3-04 * | − | − | − | − | − | − | − | − | − | ||
| 4 | AP3-43 * | Leifsonia sp. (AB016985.1), 95 | − | − | − | − | − | − | − | − | − |
| 5 | AP1-11 * | Carnobacterium viridans (AF425608.1), 99 | − | + | + | − | − | − | − | − | − |
| 6 | AP4-12 | n.d | + | − | − | − | − | − | − | − | − |
| 7 | AP3-30 | n.d | − | − | − | − | − | − | − | − | − |
| 8 | AP3-32 | n.d | − | − | − | − | − | − | − | − | − |
| 9 | AP1-41 * | Rhodococcus hoagi (X82052.1), 99 | − | − | − | − | − | − | − | − | − |
| 10 | AP2-01 | Rhodococcus hoagi (X82052.1), 99 | + | − | − | − | − | − | − | − | − |
| AP1-25 * | + | + | − | − | − | − | − | − | |||
| 11 | AP2-04 * | Rhodococcus hoagi (X82052.1), 100 | − | − | − | − | − | − | − | − | − |
| 12 | AP2-44 * | Paenibacillus illinoisensis (AB073192.1), 99 | − | − | − | − | − | − | − | − | − |
| 13 | AP1-17 * | Rhodococcus hoagi (X82052.1), 99 | − | − | + | − | − | − | − | − | − |
| 14 | AP2-34 | n.d | − | − | − | − | − | − | − | − | − |
| 15 | AP2-13 | Bacillus aerius (AJ831843.1), 99 | + | − | − | − | − | − | − | − | − |
| AP2-06 | − | - | − | − | − | − | − | − | − | ||
| AP4-14 * | + | + | + | − | − | − | − | − | − | ||
| 16 | AP2-36 * | Bacillus pumilus (AY876289.1), 99 | − | − | + | + | + | + | + | + | + |
| 17 | AP2-15 | n.d | − | − | − | − | − | − | − | − | − |
| 18 | AP4-03 * | Bacillus thuringiensis (CP053934.1), 99 | − | − | − | + | + | + | + | + | + |
| 19 | AP4-05 | Agreia pratensis (AJ310412.1), 99 | − | − | − | − | − | − | − | − | − |
| AP1-07 | − | − | + | − | − | − | − | − | − | ||
| AP1-22 | − | − | + | − | − | − | − | − | − | ||
| AP3-42 * | − | − | − | − | − | − | − | − | − | ||
| AP4-09 | − | − | − | − | − | − | − | − | − | ||
| 20 | AP4-10 | n.d | + | − | − | − | − | − | − | − | − |
| 21 | AP4-24 * | Arthrobacter cupressi (HQ657321.1), 99 | − | − | − | − | − | − | − | − | − |
| 22 | AP4-20 | Agreia pratensis (AJ310412.1), 99 | + | − | − | − | − | − | − | − | − |
| AP4-28 | − | − | − | − | − | − | − | − | − | ||
| AP1-27 * | + | − | − | − | − | − | − | − | − | ||
| AP1-26 | − | − | − | − | − | − | − | − | − | ||
| 23 | AP1-23 * | Mycoplana ramosa (D13944.1), 99 | − | − | − | − | − | − | − | − | − |
| 24 | AP3-38 * | Agreia pratensis (AJ310412.1), 98 | − | − | − | − | − | − | − | − | − |
| 25 | AP3-29 * | Rhodococcus hoagi (X82052.1), 99 | − | − | − | − | − | − | − | − | − |
| 26 | AP3-31 * | Rhodococcus hoagi (X82052.1), 99 | − | − | − | − | − | − | − | − | − |
| 27 | AP2-45 * | Rhodococcus hoagi (X82052.1), 100 | − | − | − | − | − | − | − | − | − |
| 28 | AP1-16 * | Agreia pratensis (AJ310412.1), 99 | − | − | − | − | − | − | − | − | − |
| AP1-19 | − | − | − | − | − | − | − | − | − | ||
| 29 | AP2-02 | Agreia pratensis (AJ310412.1), 99 | − | − | − | − | − | − | − | − | − |
| AP2-08 * | − | − | − | − | − | − | − | − | − | ||
| AP2-18 | − | + | − | − | − | − | − | − | − | ||
| Strain | IAA Concentration (µg/mL) | AMS Production | ||
|---|---|---|---|---|
| Fungal Mycelium Inhibition (%) | Inhibition by Bacterial Extracts (%) | |||
| Inhibition Halo
Diameter (mm) | IC (%) | |||
| AP4-03 | 1.45± 0.06 b | 69.02 ± 3.08 a | 23.33 ± 0.94 a | 96.25 ± 2.75 a (50 mg/mL) |
| AP1-33 | 1.35 ± 0.07 b | 67.13 ± 5.57 a | 20.00 ± 0.81 ab | 92.89 ± 3.21 a (50 mg/mL) |
| AP2-36 | 2.02 a ± 0.10 a | 70.64 ± 4.95 a | 18.66 ± 2.62 b | 100.00 ± 1.90 a (41 mg/mL) |
| Control | 0.00 ± 0.00 c | 0.00 ± 0.00 c | 0.00 ± 0.00 c | 0.00 ± 0.00 c (0 mg/mL) |
| Treatment | Nº Roots | Root Length (cm) | Hypocotyl Length (cm) |
|---|---|---|---|
| AP4-03 | 3.88 ± 1.00 a | 2.29 ± 0.60 ab | 1.93 ± 0.50 ab |
| AP1-33 | 3.80 ± 0.69 a | 2.60 ± 0.60 a | 2.17 ± 0.50 a |
| AP2-36 | 3.98 ± 0.70 a | 2.40 ± 0.70 ab | 2.16 ± 0.50 a |
| Consortium | 3.84 ± 0.64 a | 2.40 ± 0.70 ab | 2.14 ± 0.50 a |
| Control | 3.64 ± 0.97 a | 2.20± 0.70 b | 1.74 ± 0.60 b |
Disclaimer/Publisher’s Note: The statements, opinions and data contained in all publications are solely those of the individual author(s) and contributor(s) and not of MDPI and/or the editor(s). MDPI and/or the editor(s) disclaim responsibility for any injury to people or property resulting from any ideas, methods, instructions or products referred to in the content. |
© 2024 by the authors. Licensee MDPI, Basel, Switzerland. This article is an open access article distributed under the terms and conditions of the Creative Commons Attribution (CC BY) license (https://creativecommons.org/licenses/by/4.0/).
Share and Cite
Garcias, J.T.; de Sousa, R.d.S.d.R.; Sousa, S.M.d.N.; Madeira, L.D.P.d.S.; Lima, A.L.A.; Mateus, J.R.; da Silva, J.K.d.R.; Seldin, L.; Rogez, H.L.G.; Marques, J.M. Bacillus Strains Isolated from Agroforestry Systems in the Amazon Promote Açaí Palm Seedling Growth When Inoculated as a Consortium. Agronomy 2025, 15, 569. https://doi.org/10.3390/agronomy15030569
Garcias JT, de Sousa RdSdR, Sousa SMdN, Madeira LDPdS, Lima ALA, Mateus JR, da Silva JKdR, Seldin L, Rogez HLG, Marques JM. Bacillus Strains Isolated from Agroforestry Systems in the Amazon Promote Açaí Palm Seedling Growth When Inoculated as a Consortium. Agronomy. 2025; 15(3):569. https://doi.org/10.3390/agronomy15030569
Chicago/Turabian StyleGarcias, Josinete Torres, Rosiane do Socorro dos Reis de Sousa, Suania Maria do Nascimento Sousa, Lucimar Di Paula dos Santos Madeira, Allana Laís Alves Lima, Jackeline Rosseti Mateus, Joyce Kelly do Rosário da Silva, Lucy Seldin, Hervé Louis Ghislain Rogez, and Joana Montezano Marques. 2025. "Bacillus Strains Isolated from Agroforestry Systems in the Amazon Promote Açaí Palm Seedling Growth When Inoculated as a Consortium" Agronomy 15, no. 3: 569. https://doi.org/10.3390/agronomy15030569
APA StyleGarcias, J. T., de Sousa, R. d. S. d. R., Sousa, S. M. d. N., Madeira, L. D. P. d. S., Lima, A. L. A., Mateus, J. R., da Silva, J. K. d. R., Seldin, L., Rogez, H. L. G., & Marques, J. M. (2025). Bacillus Strains Isolated from Agroforestry Systems in the Amazon Promote Açaí Palm Seedling Growth When Inoculated as a Consortium. Agronomy, 15(3), 569. https://doi.org/10.3390/agronomy15030569

